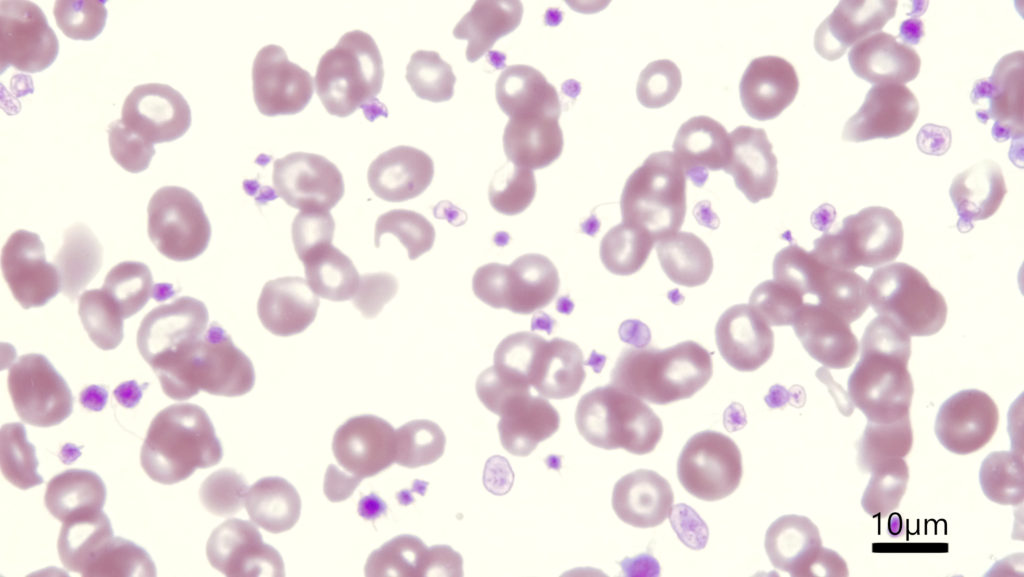

顕微鏡写真: 血小板の数え方
先日、私の所属する日本獣医輸血研究会で血液についてお話させていただいた際、フロアの方から血液塗抹での血小板数の数え方についてご質問をいただきました。獣医療では、対物レンズ100倍で赤血球が重層していない観察に適した視野(モノレイヤー、カウンティングエリア)で血小板を数えて、×15,000を計算すると1µLあたりの血小板数が概算できると言われています。たとえば5視野の血小板の平均が30個であれば、450,000/µLと推測されるわけですね。
フローサイトメトリー法ではなくインピーダンス法の自動血球計数器では、特に大型血小板の症例や猫は血小板数が偽性低値で出てくることがありますし、いずれにしても血小板数が低値で出てきたら血液塗抹で血小板の形態や数を必ず確認するようにしています。なので昔からこの血液塗抹での血小板数の概算法を愛用してきて特に不自由を感じたことはなかったのですが、件の質問をされた先生はどうもその概算法は数値のばらつきが出て自動血球計数器の数値とも乖離がみられると。
その先生は人の医療の方で昔用いられていたFonio法と呼ばれる血小板数の概算法を採用されているそうで。その方法では赤血球を1,000個数える間に遭遇する血小板の数を数え、別途自動血球計数器などで算出されている赤血球数から比例で血小板数を求めるものになります。たとえば、血液塗抹で赤血球を1,000個数える間に出会った血小板の数が50個かつ自動血球計数器の赤血球数が600万/µLであれば、50×600万/µL÷1,000で30万/µLというわけです。
ただ、その先生とお話をしていて途中で分かったのは、その先生の施設では血液塗抹をあわせガラス法(圧挫伸展標本、クラッシュ標本)で作られていたということでした。血液塗抹を作る方法は医療、獣医療問わず一般的に引きガラス法(ウェッジ標本)なのですが、日本の獣医療ではあわせガラス法で血液塗抹を作る施設が一定数存在しています。だから血小板数がずれるんですかねぇとその先生と議論をしてその場はおしまいになりました。
そこで、今回は手元にあった血液で血小板数を色々と数えてみました。よりによって貧血かつ血小板数増加症例だったので数えるのが大変でした。。。気を取り直して結果の発表です。引きガラス法の血小板数は×15,000する方法で126万/µL、Fonio法で88万/µL。あわせガラス法の血小板数は×15,000する方法で143万/µL、Fonio法で132万/µL。そして、気になる自動血球計数器の血小板数は・・・68万/µL。え、どの方法も自動血球計数器の測定値と全然違う。強いてあげれば引きガラス法の血液塗抹に対してFonio法で数えたのが最も近いですね。

しかしながら頑張って人力でカウントした私としては、自動血球計数器の数値が測定エラーなんじゃないかと思いたいレベルで数値がズレていますね。おかしいなぁ。血小板数低値の症例では結構数値が近しい値で概算できる気がするんだけどなぁ。概算法だから細かい数値の違いは仕方ないのかもしれないですが。ちなみに、質問してくれた先生も仰っていましたが、赤血球を1,000個数えるのは夢でうなされるほど大変で、診療しながらのFonio法はやってられないですね。
あとやっていて分かったのは、あわせガラス法は血球が円形に広がっていて分布が独特で、同じ分布条件で観察できるエリアを探すのが難しいように思いました。たとえば、とある視野では血小板の数が102、105、109個だったのですが、少しそのまま視野を進めていくと95個、67個のエリアに遭遇しました。一応、赤血球の分布がモノレイヤー風のところを選んで計測していたのですが、それでも結構血小板数にばらつきが多かった印象です。やはり血液塗抹は引きガラス法で作った方が見やすいなぁと思いました。
以上です。いつかこの記事が質問して下さった先生の目に留まることを期待しています。結論としては、あくまで血液塗抹では血小板が多いか少ないか、くらいのコメントに留めた方が良いみたい、ということです笑


